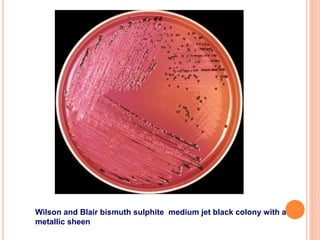
Wilson and Blair bismuth sulphite medium jet black colony with a
metallic sheen

Embed presentation
Downloaded 215 times
























































Mary Mallon was a cook who was the first identified healthy carrier of typhoid fever. In 1906, she worked for a family where several members contracted typhoid. An investigation found Mallon to be the source, though she did not show symptoms. She was quarantined from 1907 to 1910. After her release, she obtained work under an alias as a cook and infected over 20 people. She was then permanently isolated from 1915 until her death in 1938. Typhoid fever remains endemic in parts of Asia and Africa, with over 16 million cases estimated annually. Diagnosis involves blood and stool cultures while treatment is usually with antibiotics like ciprofloxacin or azithromycin. Complications can include intestinal perforation or